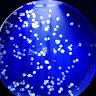
Profile Picture of Christian Ebsen (@drebsen) on Pinterest

Chris Allen Ebsen, age 58, Aurora, CO View Details
Cities: Aurora CO, Corvallis MT Possible Relatives: Christina R Beers, Duane Edward Drayer, Bonnie Marie Ebsen
Christine Marie Ebsen, age 51, Watertown, SD View Details
Cities: Aurora CO, Corvallis MT Possible Relatives: Christina R Beers, Duane Edward Drayer, Bonnie Marie Ebsen
Chris Ebsen, age 53, Grafton, WI View Details
Cities: Aurora CO, Corvallis MT Possible Relatives: Christina R Beers, Duane Edward Drayer, Bonnie Marie Ebsen
Chris David Ebsen, age 55, El Mirage, AZ View Details
Cities: Aurora CO, Corvallis MT Possible Relatives: Christina R Beers, Duane Edward Drayer, Bonnie Marie Ebsen
Chris David Ebsen, age 45, Silver Springs, NV View Details
Cities: Aurora CO, Corvallis MT Possible Relatives: Christina R Beers, Duane Edward Drayer, Bonnie Marie Ebsen
Chris J Ebsen, age 33, Waukesha, WI View Details
Cities: Aurora CO, Corvallis MT Possible Relatives: Christina R Beers, Duane Edward Drayer, Bonnie Marie Ebsen
Chris Jon Ebsen, age 72, Fargo, ND View Details
Cities: Aurora CO, Corvallis MT Possible Relatives: Christina R Beers, Duane Edward Drayer, Bonnie Marie Ebsen
Chris E Ebsen, age 69, Milbank, SD View Details
Cities: Aurora CO, Corvallis MT Possible Relatives: Christina R Beers, Duane Edward Drayer, Bonnie Marie Ebsen
Christian M Ebsen, Marion, IA View Details
Cities: Aurora CO, Corvallis MT Possible Relatives: Christina R Beers, Duane Edward Drayer, Bonnie Marie Ebsen
Chris Jon Ebsen, age 72, Fargo, ND View Details
Locations: Aurora CO, Corvallis MT Possible Relatives: Christina R Beers, Duane Edward Drayer
Chris E Ebsen, age 69, Milbank, SD View Details
Locations: Aurora CO, Corvallis MT Possible Relatives: Christina R Beers, Duane Edward Drayer
Chris Allen Ebsen, age 58, Aurora, CO View Details
Locations: Aurora CO, Corvallis MT Possible Relatives: Christina R Beers, Duane Edward Drayer
Chris David Ebsen, age 55, El Mirage, AZ View Details
Locations: Aurora CO, Corvallis MT Possible Relatives: Christina R Beers, Duane Edward Drayer
Chris Ebsen, age 53, Grafton, WI View Details
Locations: Aurora CO, Corvallis MT Possible Relatives: Christina R Beers, Duane Edward Drayer
Christine Marie Ebsen, age 51, Watertown, SD View Details
Locations: Aurora CO, Corvallis MT Possible Relatives: Christina R Beers, Duane Edward Drayer
Chris David Ebsen, age 45, Silver Springs, NV View Details
Locations: Aurora CO, Corvallis MT Possible Relatives: Christina R Beers, Duane Edward Drayer
Chris J Ebsen, age 33, Waukesha, WI View Details
Locations: Aurora CO, Corvallis MT Possible Relatives: Christina R Beers, Duane Edward Drayer
Christian M Ebsen, Marion, IA View Details
Locations: Aurora CO, Corvallis MT Possible Relatives: Christina R Beers, Duane Edward Drayer
Chris D Ebsen, age 30s, Reno, NV View Details
Locations: Reno NV, Silver Springs NV Possible Relatives: Debra L Ebsen, Debra Ebsen, Jilian Marie Ebsen
C Ebbesen, age 40s, North Richland Hills, TX View Details
Locations: North Richland Hills TX, Hurst TX
Chris D Ebsen, age 40s, Peoria, AZ View Details
Locations: Peoria AZ, Stoughton WI Possible Relatives: Edward A Rudinsky, Krystal J Rudinsky, Melissa Ann Rudinsky
Chris Ibsen, age 40s, Buffalo, NY View Details
Locations: Buffalo NY, Brooklyn NY
Todd Lori Ebbesen, age 40s, Longmont, CO View Details
Locations: Longmont CO, Erie CO, Green Valley AZ Possible Relatives: Donna Joanne Ebbesen, Gary D Ebbesen, Lori Ann Ebbesen
Chris A Ebsen, age 40s, Aurora, CO View Details
Locations: Aurora CO, Bennett CO Possible Relatives: Duane Edward Drayer, Bonnie M Ebsen, Heidi M Ebsen
Chris E Ebsen, age 60s, Milbank, SD View Details
Locations: Milbank SD, Revillo SD Possible Relatives: Crystal E Ebsen, Gary W Ebsen, Jason Gary Ebsen
Address:***** Aspen Dr, Milbank, SD. Phone Number: (605) 432-****
Address:***** W Cota St, Trlr 2x, Shelton, WA. Phone Number: (360) 490-****
Address:***** Highway 7x, Bennett, CO. Phone Number: (303) 261-****
Address:***** Church St, Apt 4, Allenton, WI. Phone Number: (262) 644-****
Address:***** Milhof Dr, Dallas, TX. Phone Number: (720) 364-****
Search locality history, phone, age and more.

Chris Ebsen • chris.ebsen


Chris Ebsen • Chris-Ebsen


Chris Ebsen • Chris-Ebsen


Chris Ebsen • atthelakewithbear


Chris Essen • Chris-Essen


Christian Ebsen • Christian-Ebsen


Christian Ebsen • christian.ebsen.14


Christian Ebsen • christian.ebsen.50


Christopher Ibsen • Christopher-Ibsen


Christian Eisen Requiron • Christian-Eisen-Requiron


Christopher Ebuen • christopher.ebuen.664445


Christel Von Essen • Christel-Von-Essen


Chris Kian Elisen Lanoy • Chris-Kian-Elisen-Lanoy


Chris Essen • Chris-Essen


Chris Ibsen • Chris-Ibsen


Chris Ebsen • chris.ebsen

Chris Ebsen • ebsen_chris

Christel Ebsen • cebyfornyelse

Christian Ebsen • chrisebsen

Christian Ebsen • christian.ebsen

Christian Ebsen • christian_edirty6

Christina Ebsen • christina_ebsen

Christian • ebsen.fcs

Chris • chris_ebsen

Chris • ebsenchris

Christy Ebsen Floyd • floydchristy

Marie Christin Ebsen • marie_ebsen_

Christian Eberhardt • ebsen101

ebsenchristina • ebsenchristina

Christina Grønbæk Ebsen • christinaebsen

Anette Ebsen Christiansen • anette2311

Chris Eben • chris.eben

Chris Erbsen • chriserbsen

Chris Olsen • chris

chris.ebsn • chris.ebsn

Chris_Ebs • chrisebs_

Chrissebassen • chrissebassen

chrisebassen • chrisebasssen

Christoffer • chrisebassen

not chris olsen • notolsennchris

Damon501 • chrisebsen1

Chris Ebsen • CjEbsen

Chris Ebsen • cebsen32

Chris • ChrisEbsen

Von Christopher • VonEbsen
Christian Ebsen • drebsen

Christine Ebsen • cebsen

Christine Ebsen • cmebsen

Chris Ebsen • chris-ebsen

Clint Ebsen • c_ebsen

Carmen Ebsen • carmenebsen

Christine Ebsen • cebsen

Christine Ebsen • christineebsen

Halie Ebsen • halieebsen

Katie Ebsen • kebsen

Teni Ebsen • teniebsen

Allison Ebsen • aliebsen

Elaina Ebsen • elaina_ebsen

Ethan Ebsen • ethanebsen

Rachel Ebsen • r_ebsen

Rylee Ebsen • ryleeebsen

Angela Ebsen • asebsen

Caitlyn Ebsen • caitlynebsen

Kirsten Ebsen • klebsen

Nicole Ebsen • naebsen

Reagan Ebsen • reaganelise__

Kristina Ebsen • sundevil2113

Jennifer Ebsen • jennaebsen

Kayleigh Ebsen • kbug_26

Chris Ebsen • ChrisEbsen

Chris Eisen • chris_eisen

Chris Elsen • 262044495

Chris Elsen • chriselsen

Chris Been • seelynch

Chris Ebbe • 401374863

Chris Ebel • cebel

Chris Ebner • skunk132

Chris Eden • djchriseden

Christopher Ebey • chrisebey
The Wizard Of Oz's Original Tin Man Buddy Ebsen Was …
www.msn.com › en-us › movies › news › the-wizard...
· Ebsen eventually retired from acting in his elder years and his final project was a guest voice acting role in King of the Hill in the late 1990s. Ebsen passed away in July 2003 at 95 years of age.
Whatever Happened To Buddy Ebsen From 'The Beverly …
doyouremember.com › 149940 › whatever-happened-to-buddy-ebsen
CONTACT US AUTHORS Stories Whatever Happened To Buddy Ebsen From ‘The Beverly Hillbillies’? In 1962, Buddy Ebsen grew to fame as Jed Clampett in The Beverly …
Was Buddy Ebsen the Original 'Wizard of Oz' Tin Man?
www.snopes.com › fact-check › buddy-ebsen
en.wikipedia.org › wiki › Buddy_Ebsen
Actor Buddy Ebsen Dies - CBS News
www.cbsnews.com › news › actor-buddy-ebsen-dies
· Buddy Ebsen, the loose-limbed dancer turned Hollywood actor who achieved stardom and riches in the television series "The Beverly Hillbillies" and "Barnaby Jones," …
en.wikipedia.org › wiki › Max_Baer_Jr.
Maximilian Adelbert Baer Jr. (born December 4, 1937) is an American actor, producer, comedian, and director widely known for his role as Jethro Bodine, the dim-witted relative …
Buddy Ebsen - Biography - IMDb
www.imdb.com › name › nm0001171 › bio
Birth name Christian Ludolf Ebsen Jr. Height 6′ 3″ (1.91 m) Mini Bio Buddy Ebsen began his career as a dancer in the late 1920s in a Broadway chorus. He later formed a vaudeville act with his sister Vilma Ebsen, …
en.wikipedia.org › wiki › Fess_Parker
Fess Elisha Parker Jr. (born F. E. Parker Jr.; [1] August 16, 1924 – March 18, 2010), [2] was an American film and television actor best known for his portrayals of the titular …
www.imdb.com › name › nm0262635
Christopher Robert Evans is an American actor, film producer, and director. Evans began his acting career in typical fashion: performing in school productions and …
Chris Evans - Biography - IMDb
www.imdb.com › name › nm0262635 › bio
Christopher Robert Evans is an American actor, film producer, and director. Evans began his acting career in typical fashion: performing in school productions and community …
What's Chris Ebsen's address?
Chris Ebsen's address is ***** Aspen Dr, Milbank, SD.
What's Chris Ebsen's phone number?
Chris Ebsen's phone number is (605) 432-****.
What's Chris Ebsen's Instagram?
We've discovered several social media accounts associated with Chris Ebsen, including @chris.ebsen, @ebsen.fcs, @chris_ebsen, @christinaebsen and others. To explore more of Chris Ebsen's online presence, click here.
What's Chris Ebsen's Facebook?
We've discovered several social media accounts associated with Chris Ebsen, including @chris.ebsen, @Chris-Ebsen, @Chris-Ebsen, @atthelakewithbear and others. To explore more of Chris Ebsen's online presence, click here.
Are PeekYou social results accurate?
PeekYou is a free people-focused search engine that uncovers information typically buried by other search engines. Its clean and user-friendly format makes it easy to navigate. The platform offers accurate data and conveniently links to an individual's social media profiles and other public websites with which they are associated.